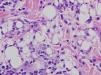
fig0030

Se presenta el caso clínico de una paciente que ingresó en nuestro servicio por clínica de poliartralgias, fiebre y lesiones cutáneas que afectaban a la región glútea y pretibial. Refería como antecedente la aplicación de inyecciones de silicona líquida en los glúteos con fines estéticos 3 años antes. Se realizó una biopsia cutánea de las lesiones en la región glútea, cuyo estudio anatomopatológico fue compatible con paniculitis facticia por silicona, así como de la región pretibial, que fueron compatibles con eritema nudoso. La radiografía de tórax y la tomografía torácica mostraron adenopatías hiliares bilaterales y en la biopsia transbronquial se evidenció un componente inflamatorio granulomatoso. La evolución fue satisfactoria con reposo y antiinflamatorios no esteroideos, por lo que no fue necesaria la extracción de la silicona.
We herein report a patient who came to the hospital because of a polyarticular joint pain, fever and cutaneous lesions. She had silicone implants in her buttocks, a surgery performed 3 years before. We made a biopsy of the skin of the buttocks (facticial panniculitis due to silicone) and of the pretibial surface of the inferior extremities (erythema nodosum). A chest X- ray and a CT scan revealed bilateral hiliar lymphadenopathy, and a transbronquial biopsy showed granulomatous inflammation. She had a good response to rest and anti-inflammatory drugs, so the removal of the silicone implants has not been necessary yet.
Las prótesis o inyecciones de silicona se emplean con fines estéticos para aumentar volumen de tejidos o corregir cicatrices. Aunque la silicona se ha considerado como material inerte, en la actualidad se sabe que puede producir reacciones indeseables a nivel local o sistémico, con una latencia incluso de décadas. Entre las reacciones locales se encuentra la paniculitis inducida por cuerpo extraño o paniculitis facticia1 y entre las reacciones sistémicas se ha descrito en algunos casos la aparición de conectivopatías2.
En los últimos años se describen en la literatura varios casos de sarcoidosis que se presentaron tras la inyección de silicona en diversos lugares del organismo con fines estéticos3-8. En la mayoría de estos casos fue necesario el uso de corticoides sistémicos para control de los síntomas, junto con la extracción de la silicona.
Se describe el caso de una paciente que, tras la inyección de silicona líquida, presentó una complicación local (paniculitis facticia) junto con otra complicación sistémica (síndrome de Löfgren).
Caso clínicoSe trata de una mujer de 44 años, sin antecedentes médico-quirúrgicos de interés, natural de Colombia, residente en España desde hace 10 años. Refiere antecedente de inyecciones de silicona líquida en las nalgas 3 años antes en su país (Colombia).
Ingresa en el servicio de reumatología por cuadro de artralgias en las rodillas, con posterior afectación de tobillos, codos y muñecas de una semana de evolución, junto con la aparición de lesiones cutáneas sobreelevadas, eritematosas, no pruriginosas, dolorosas, en ambas nalgas (fig. 1) y febrícula (37,6°C). La paciente no refiere síndrome general ni rigidez matutina, no presenta clínica sugestiva de foco infeccioso y niega viajes al extranjero en los últimos meses, así como el consumo de tóxicos.
En la exploración física se encuentra hemodinámicamente estable, afebril y presenta buen estado general. La exploración física general es normal y en la exploración musculoesquelética destaca un aumento de temperatura local a nivel de ambas rodillas, con dolor a la flexoextensión, sin eritema ni derrame articular, junto con tumefacción y aumento de la temperatura local a nivel de ambos tobillos. En cuanto a la exploración dermatológica, presenta lesiones papulosas eritematosas, dolorosas a la palpación, induradas al tacto, a nivel de ambas nalgas.
Como pruebas complementarias, se solicita una analítica, donde se objetiva una anemia con un hematocrito de 27,7% (vn 36-45) y una hemoglobina de 9,4g/dl (vn 12-16); normocítica y normocrómica, junto con una cifra de plaquetas de 540.000 (vn 130-450). Se realiza un estudio de la anemia, objetivándose un déficit de hierro (Fe: 18; vn 37-145) con ferritina, vitamina B12, ácido fólico y proteinograma normales, y un frotis de sangre periférica en el que solo destaca una discreta basofilia. En el resto de los estudios analíticos se objetiva asimismo un hipotiroidismo subclínico, con una TSH discretamente elevada y hormonas tiroideas normales que, consultado con el servicio de endocrinología, no precisó tratamiento sustitutivo. No se observan leucocitosis ni desviación izquierda y las funciones renal y hepática, los iones y la coagulación son normales. Como reactantes fase aguda, presenta una velocidad de sedimentación globular de 110mmHg y una proteína C reactiva 28,8mg/dl. En el estudio de autoinmunidad presenta un factor reumatoide de 24 U/l, anticuerpos antinucleares 1/80, siendo los anticuerpos anticitoplasma de neutrófilo negativos. La enzima convertidora de angiotensina (ECA) se encuentra dentro de valores normales (ECA: 38; vn 18-58). Se solicitan hemocultivos, que fueron negativos, y un sedimento de orina, que fue normal. Las serologías solicitadas, hepatitis, virus de la inmunodeficiencia humana, rubéola, citomegalovirus, virus de Epstein-Barr, Toxoplasma, Treponema pallidum, Borrelia, Mycoplasma y Chlamydia, fueron negativas. Se realiza una radiografía de tórax donde se visualizan adenopatías hiliares bilaterales (fig. 2). Para descartar una posible tuberculosis se solicitan una prueba de Mantoux que fue negativa y auraminas en orina seriadas, que también fueron negativas.
Se realiza una TC de alta resolución, que resulta compatible con una sarcoidosis de grado I (adenopatías hiliares bilaterales y en mediastino) (fig. 3). En la biopsia transbronquial se objetiva un componente inflamatorio y en el lavado broncoalveolar existe un cociente de CD4/CD8 de 5,26, con un 80% de histiocitos, un 15% de linfocitos y un 5% de neutrófilos.
Durante el ingreso aparecen, además, lesiones nodulares palpables, eritematosas y dolorosas en región pretibial de ambos miembros inferiores (fig. 4). Se lleva a cabo una interconsulta con dermatología, que realiza una biopsia de las lesiones cutáneas de las nalgas y los miembros inferiores. En la anatomía patológica de las lesiones de las nalgas se observan gran cantidad de histiocitos, cargados de vacuolas citoplasmáticas con contenido lipídico afectando a los septos y el panículo adiposo, lo que es compatible, dado el contexto clínico, con paniculitis facticia por silicona (fig. 5). En cambio, en la biopsia de la piel a nivel pretibial se objetiva una paniculitis mixta, preferentemente septal, con granulomas, sin necrosis, hallazgos compatibles con eritema nodoso, sin evidencia de implante de silicona (fig. 6). Las tinciones de Ziehl-Neelsen y PAS son negativas.
Se instaura tratamiento con antiinflamatorios no esteroideos (indometacina a dosis de 50mg/8h), con muy buena respuesta clínica, manteniéndose afebril, con disminución de la tumefacción a nivel maleolar, así como desaparición progresiva de las lesiones cutáneas.
Posteriormente, se realizaron revisiones en los servicios de reumatología, dermatología y neumología, encontrándose la paciente asintomática. No volvió a presentar nuevos brotes a pesar de que no se le extrajeron los implantes de silicona.
DiscusiónLa sarcoidosis es una enfermedad granulomatosa multisistémica, de etiología desconocida, que afecta sobre todo a jóvenes, y cuyas manifestaciones clínicas más frecuentes son adenopatías hiliares bilaterales, infiltrados pulmonares y lesiones cutáneas y oculares9. Se caracteriza por la formación de granulomas no caseificantes.
Löfgren, en 1946, describió por primera vez un síndrome caracterizado por la asociación de eritema nodoso y adenopatía hiliar bilateral. Este síndrome constituye una forma de sarcoidosis aguda o subaguda, de naturaleza generalmente benigna, que se suele acompañar de poliartritis/poliartralgias y de fiebre, y que se resuelve de forma espontánea9. Se suele asociar a HLA-DRB1*03.
La patogenia de la sarcoidosis está mediada por una disfunción de linfocitos T e hiperactividad de los B, de forma que este proceso sería el resultado de una respuesta inmunitaria anormal frente a diversos agentes ambientales específicos, que se comportan como antígenos y que afectan a individuos genéticamente predispuestos. En experimentos realizados con ratones se ha demostrado que la silicona es capaz de activar la respuesta humoral y de hipersensibilidad retardada, y además ejerce un efecto directo sobre los macrófagos, haciendo que liberen citocinas, con la consiguiente activación de linfocitos4. Así pues, se cree que, en una persona predispuesta, la silicona podría actuar como un antígeno desencadenante de multitud de respuestas inmunológicas y manifestaciones sistémicas4. Una amplia variedad de conectivopatías (esclerosis sistémica, lupus eritematoso sistémico, artritis reumatoide) han sido relacionadas con implantes de silicona2. En concreto, son varias las publicaciones3,5-8 que hacen referencia a la aparición de sarcoidosis o de un síndrome de Löfgren en personas previamente sanas, como nuestro caso, después de someterse a diversas intervenciones quirúrgicas, principalmente de estética, y realizarse implantes de silicona en diversas zonas corporales. En algunas de estas personas las manifestaciones resultaron especialmente graves, con un síndrome constitucional muy marcado, con fiebre, artralgias generalizadas, astenia intensa, aparición de adenopatías y lesiones cutáneas, e incluso un derrame pleural moderado3,4,7,8. En todos los casos se realizaron una radiografía de tórax y una TC torácica, y se tomó una biopsia transbronquial, de las adenopatías o de las lesiones cutáneas, que evidenciaron granulomas no caseificantes y mediante la técnica de Zhiel-Niesen se descartó tuberculosis. En la mayoría de los pacientes fue necesario, además del tratamiento con corticoides sistémicos, la extracción de los implantes de silicona, aunque en un caso no fue necesario extraerlos7.
Por otro lado, a nivel cutáneo local, las inyecciones de silicona pueden producir una reacción de cuerpo extraño, que puede extenderse hasta el tejido graso subcutáneo, originando una paniculitis facticia1.
Las lesiones aparecen generalmente meses o años después de la inyección como nódulos o placas de consistencia normalmente dura, eritematosas y dolorosas a la palpación, llegando incluso a veces a formarse úlceras por necrosis grasa10.
La histología es característica y consiste en una paniculitis lobular con células gigantes multinucleadas como una reacción a cuerpo extraño. Es frecuente encontrar dentro de las vacuolas el material de relleno, que en este caso consiste en lípidos o aceites10. La presencia de vacuolas de diferentes tamaños puede producir un aspecto típico en forma de «queso suizo».
El tratamiento etiológico (remoción del producto inyectado) puede resultar difícil, sobre todo cuando se trata de silicona líquida. Para el tratamiento sintomático se han utilizado los corticoides locales, sistémicos, la minociclina11 y el imiquimod al 5%.
Un incremento en el porcentaje de neutrófilos y células NK en líquido broncoalveolar está asociado con un pobre pronóstico y la probabilidad de mayor requerimiento de esteroides, contrariamente a lo que sucedió con esta paciente, lo que quizá contribuyó a una respuesta rápida, incluso sin necesidad de esteroides o de retirar del material.
ConclusionesLa silicona es un material utilizado frecuentemente en cirugía plástica que, como se ha observado, puede producir reacciones indeseables tanto a nivel local como sistémico.
Lo más destacable del caso que se expone es que la paciente presentó, por una parte, una reacción local en forma de paniculitis facticia (en la biopsia de la piel de las nalgas se observaron gran cantidad de histiocitos cargados de vacuolas citoplasmáticas rellenas de un material lipídico compatible con silicona) y, por otra, una reacción a distancia, un síndrome de Löfgren, con fiebre, artralgias, adenopatías hiliares y lesiones cutáneas en forma de eritema nodoso (en la biopsia de la piel de la zona pretibial se observó una paniculitis mixta septal, sin evidencia de gotas lipídicas que sugirieran implantes de silicona). A diferencia de otros casos descritos en otras publicaciones científicas, no ha sido necesario por el momento retirar la silicona ni utilizar corticoides sistémicos, puesto que evolucionó favorablemente con el empleo de antiinflamatorios.
Responsabilidades éticasProtección de personas y animales. Los autores declaran que para esta investigación no se han realizado experimentos en seres humanos ni en animales.
Confidencialidad de los datos. Los autores declaran que han seguido los protocolos de su centro de trabajo sobre la publicación de datos de pacientes y que todos los pacientes incluidos en el estudio han recibido información suficiente y han dado su consentimiento informado por escrito para participar en dicho estudio.
Derecho a la privacidad y consentimiento informado. Los autores han obtenido el consentimiento informado de los pacientes y/o sujetos referidos en el artículo. Este documento obra en poder del autor de correspondencia.
Conflicto de interesesLos autores declaran no tener ningún conflicto de intereses.